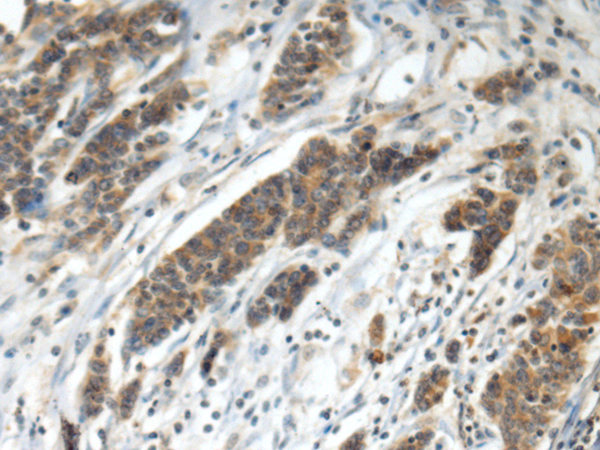

中文名稱: 兔抗HEPH多克隆抗體
儲 存: 冷凍(-20℃)
抗 原: HEPH
標 記 物: Unconjugate
克隆類型: rabbit polyclonal
技術規格
|
Background: |
This gene encodes a member of the multicopper oxidase protein family. The encoded protein is involved in the transport of dietary iron from epithelial cells of the intestinal lumen into the circulatory system, and may be involved in copper transport and homeostasis. In mouse, defects in this gene can lead to severe microcytic anemia. Alternative splicing results in multiple transcript variants. [provided by RefSeq, Aug 2013] |
|
Applications: |
ELISA, IHC |
|
Name of antibody: |
HEPH |
|
Immunogen: |
Fusion protein of human HEPH |
|
Full name: |
hephaestin |
|
Synonyms: |
CPL |
|
SwissProt: |
Q9BQS7 |
|
ELISA Recommended dilution: |
5000-10000 |
|
IHC positive control: |
Human colorectal cancer |
|
IHC Recommend dilution: |
100-300 |

購物車
購物車 幫助
幫助
 021-54845833/15800441009
021-54845833/15800441009
